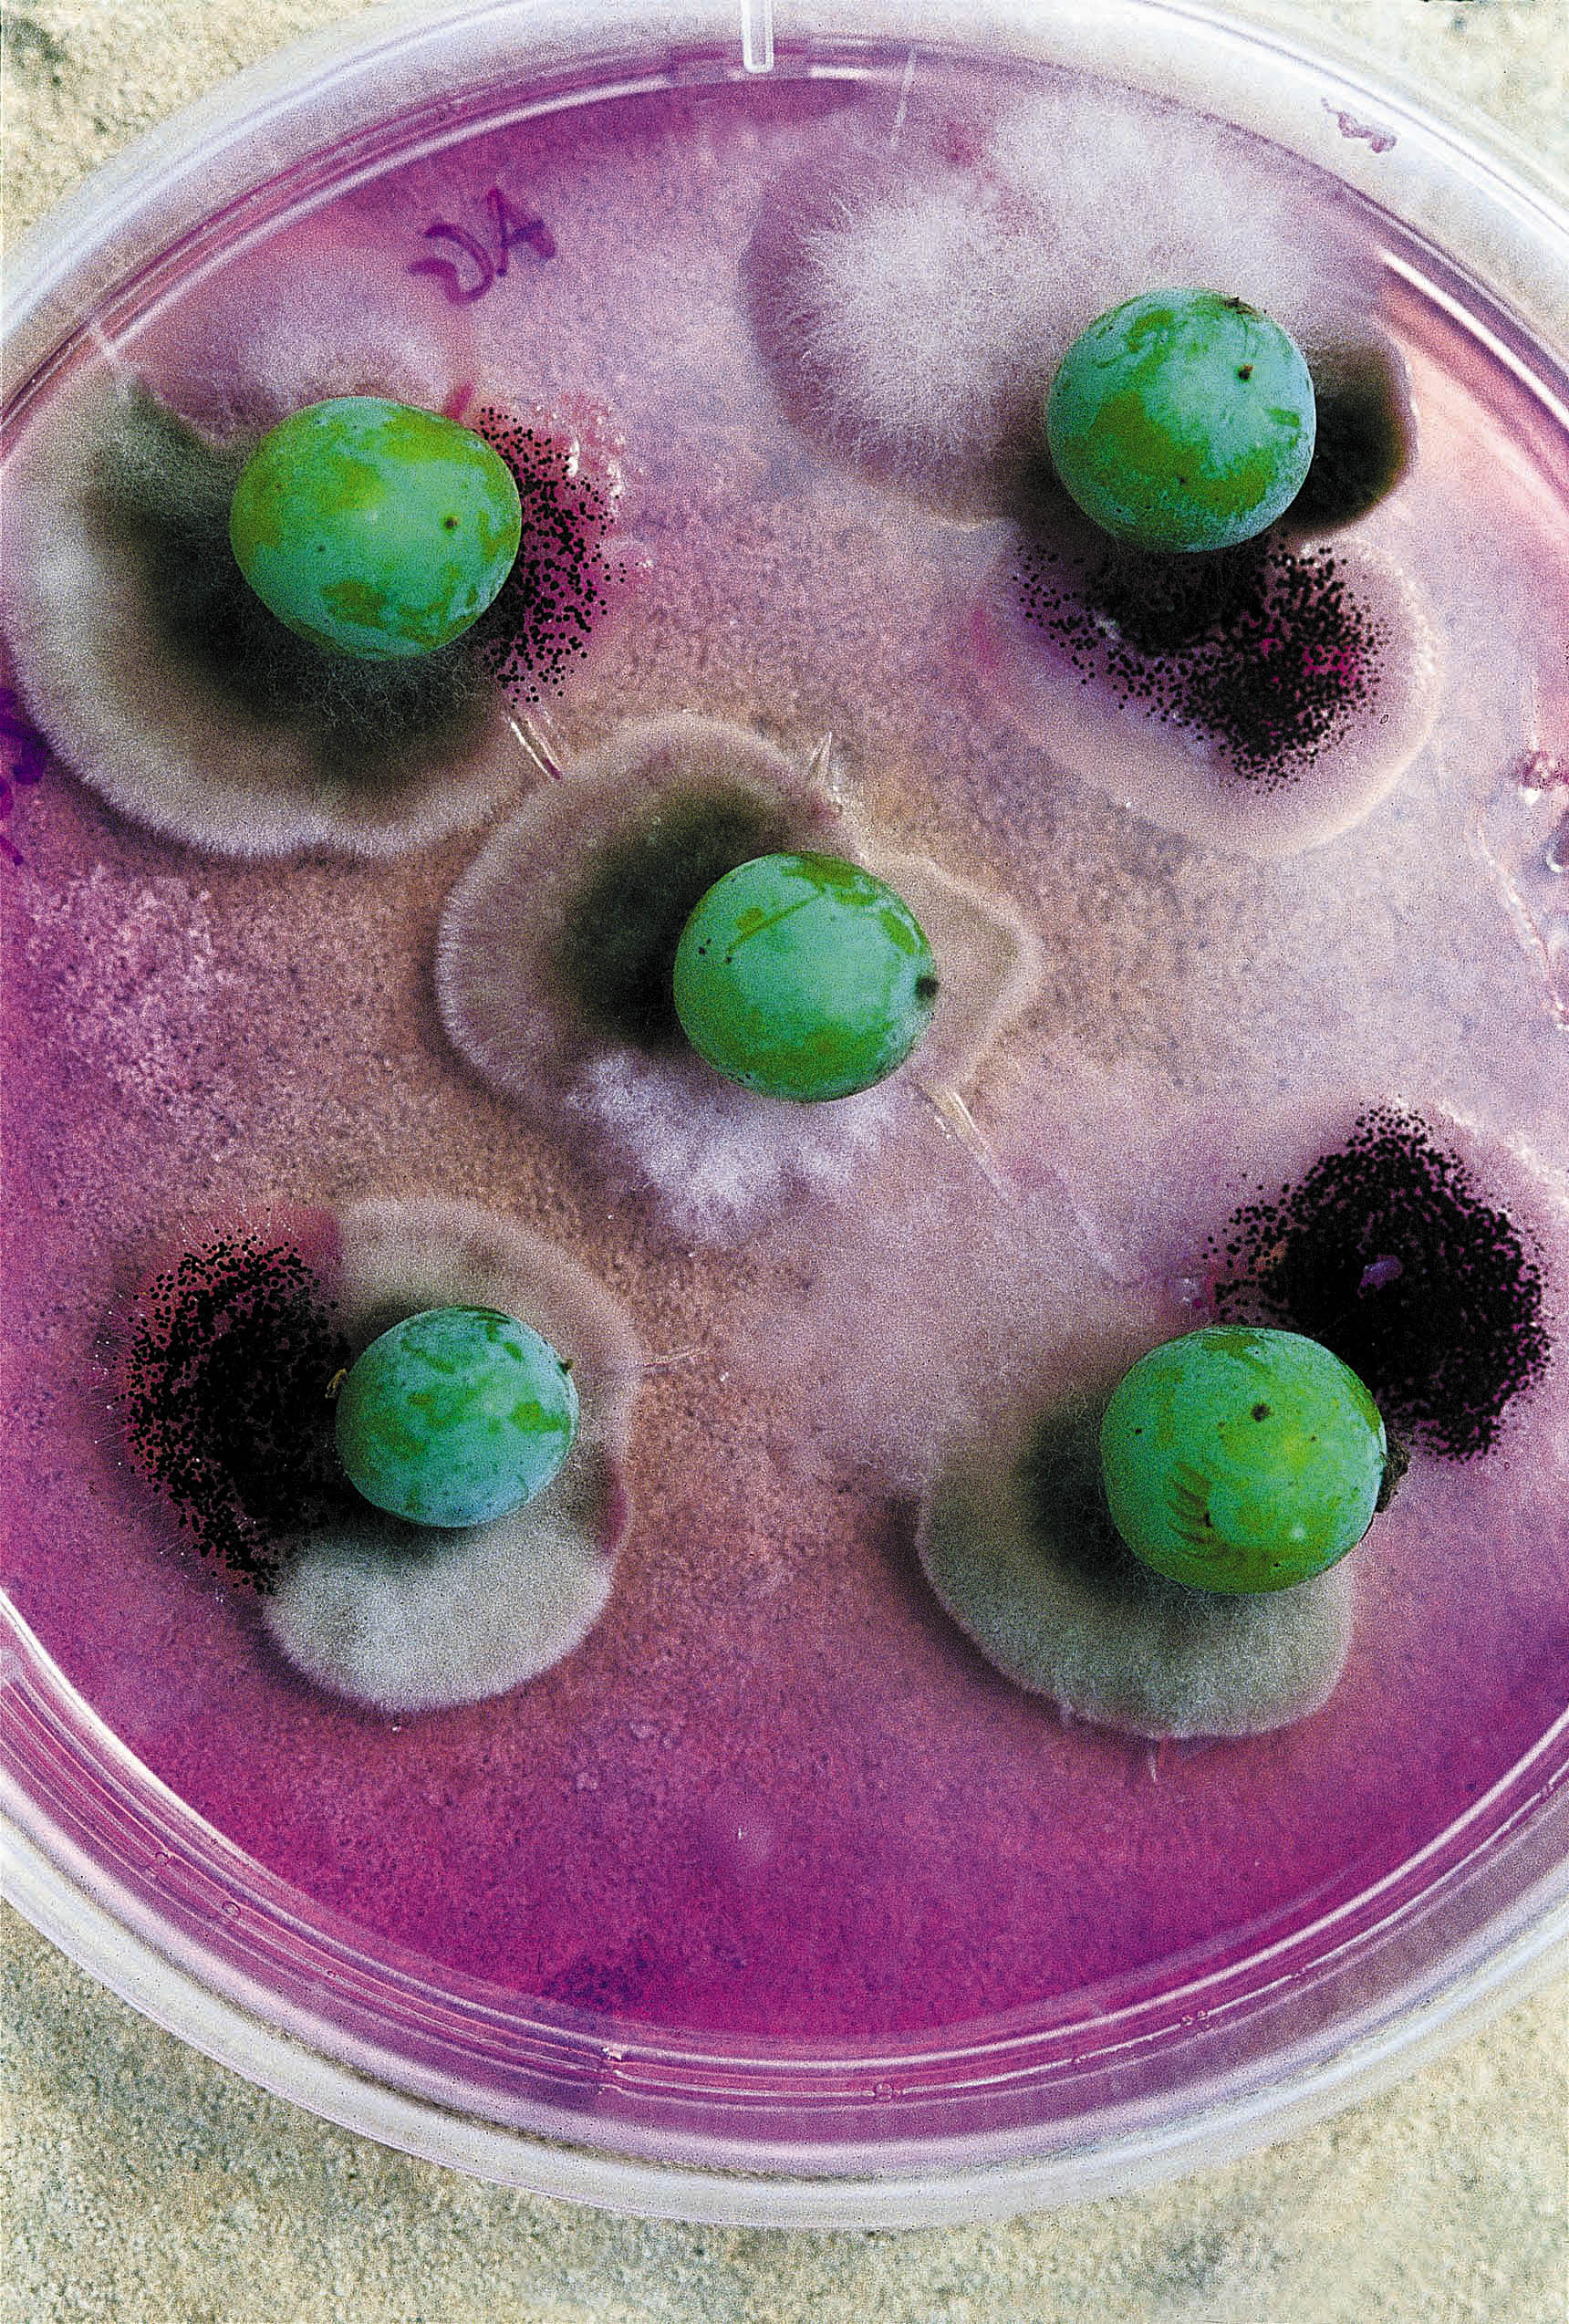
foodchain

Δέκα εκατομμύρια χρόνια πριν από σήμερα μια μετάλλαξη στα κύτταρα του πεπτικού συστήματος ενός γορίλα ή ενός χιμπαντζή θα επέτρεπε σε αυτούς τους μακρινούς προγόνους να μπορούν να τα βγάζουν πέρα με το μόριο της αιθυλικής αλκοόλης, να μην είναι δηλαδή γι’ αυτούς τοξική –άρα θανατηφόρα –ουσία, άσχετα βέβαια αν θα τους έφτιαχνε και λίγο κεφάλι –ή, αν το παραέκαναν, τότε το πολύ αλκοόλ «θα τους χτυπούσε στο κεφάλι».
Μια ομάδα ερευνητών, με επικεφαλής τον Steven Benner της Foundation for Applied Molecular Evolution, κατάφερε να φθάσει στο πώς και πότε εμφανίστηκε το πρώτο ένζυμο που ήταν σε θέση μέσα στο στομάχι πιθηκοειδών της εποχής να γίνει καταλύτης στην αποικοδόμηση του μορίου της αλκοόλης. Με άλλα λόγια, να μπορούν πλέον αυτοί οι οργανισμοί να χωνεύουν χωρίς στομαχικές ενοχλήσεις και να παίρνουν ενέργεια από τα διάφορα φρούτα που βρίσκονταν πεσμένα στον δρόμο τους, έχοντας αρχίσει να υφίστανται ζύμωση με την επίδραση διαφόρων μικροοργανισμών. Ηταν η εποχή που αφήνοντας τα κλαδιά των δέντρων κατέβηκαν και πάτησαν στο έδαφος. Στη συνέχεια άρχισαν να διανύουν αποστάσεις και το να μπορούν να τρέφονται με ό,τι βρισκόταν στον δρόμο τους έδινε ένα πλεονέκτημα σε σχέση με όποιον ακόμη επέμενε να μένει ψηλά, έχοντας όμως περιορισμένο ζωτικό χώρο και αντίστοιχα τροφή.
Η εργασία της ομάδας που δημοσιεύθηκε στο «Proceedings of the National Academy of Sciences» (Carrigan, M.A., et al. «Hominids adapted to metabolize ethanol long before human directed fermentation», 112:458, Ιανουάριος 2013), μας λέει με λίγα λόγια ότι η ικανότητα να καταναλώνουμε αλκοόλ υπήρχε πολύ πριν από ό,τι ήταν παραδεκτό ως τώρα και προήλθε από την ανάγκη να καταναλώνονται φρούτα πεσμένα από καιρό στο έδαφος χωρίς ο… καταναλωτής να οδηγείται στον θάνατο. Αν λοιπόν έχουν δίκιο οι άνθρωποι που έκαναν την έρευνα, εκτινάσσεται κυριολεκτικά το όριο των 10.000 χρόνων π.Χ., δηλαδή στη Νεολιθική Εποχή, οπότε είχαμε ενδείξεις κατανάλωσης αλκοόλ από τους προγόνους μας. Κάποια βιβλία που υποστήριξαν το αντίθετο, ότι δηλαδή πρώτα έφτιαξε ο άνθρωπος αλκοόλ και μετά άρχισε να το συνηθίζει ο οργανισμός του, θα πάρουν την ταμπέλα του «αναχρονιστικού», άλλες όμως θεωρίες θα επιβεβαιωθούν. Οπως αυτή του βιολόγου Robert Dudley, που είχε γίνει γνωστός από τη θεωρία του «drunken monkey» προσπαθώντας να εξηγήσει την αγάπη για το αλκοόλ στη Φύση. (Ναι, μεθούν ακόμη και κάποια έντομα.) Και αυτός λοιπόν πίστευε για τα πιθηκοειδή ότι μεγάλο μέρος της δίαιτάς τους αποτελούνταν από φρούτα. Οταν τα φρούτα υπερωριμάζουν, η φλούδα διαρρηγνύεται και μικροοργανισμοί όπως ο Saccharomyces Cerevisiae που παραμόνευαν απ’ έξω πιάνουν δουλειά. Και η δουλειά τους είναι να προκαλούν ζύμωση και τα σάκχαρα να μετατρέπονται σε πιο απλά μόρια όπως είναι αυτό της αιθυλικής αλκοόλης. Που έχει την επιπλέον ιδιότητα να είναι και πτητικό, δηλαδή να μπορεί να «πετάξει» στον αέρα και να ερεθίσει οργανισμούς με όσφρηση προσελκύοντάς τους προς τον συγκεκριμένο καρπό. Τροφή πολύ πιο εύκολη ως προς την πρόσβαση σε αυτήν από έναν καρπό που βρίσκεται ψηλά σε κάποιο κλαδί. Ετσι όποιος γύριζε και μύριζε και μπορούσε να καταναλώνει χωρίς επιπτώσεις είχε πιο πολλή ενέργεια και αυτό τελικά είχε θετική επίδραση και στην αναπαραγωγική ικανότητά του, άρα και την επικράτησή του.
Από εκεί και πέρα βέβαια προκύπτουν άλλα ερωτήματα. Η αιθυλική αλκοόλη, το βασικό συστατικό της ουσίας που έχουμε στο μυαλό μας με την πιο αόριστη λεκτικά σύλληψή της ως «αλκοόλ», είναι τοξική ουσία για πολλούς οργανισμούς. Γιατί όμως; Η εξήγηση γι’ αυτό είναι ότι ο Saccharomyces που προκαλεί τη ζύμωση και την παραγωγή αυτών των προϊόντων θέλει να εξουδετερώσει όποιον θα σκεφτόταν να του φάει το φαγητό του! Το κακό γι’ αυτόν είναι πως το τοξικό του προϊόν είναι μια πολύ καλή πηγή ενέργειας. Και για όποιον δεν το ξέρει αξίζει να αναφέρουμε ότι ένα μεγάλο μέρος του ανθρώπινου πληθυσμού έχει πλέον εξοικειωθεί τόσο με την αιθυλική αλκοόλη ώστε το ένα δέκατο των ενζύμων στο ανθρώπινο συκώτι να είναι επιφορτισμένο με τον μεταβολισμό αυτού ακριβώς του μορίου. Δημιουργήθηκε λοιπόν μια περίεργη σχέση δούλου – αφέντη ανάμεσα σε εμάς και στους μύκητες. Γι’ αυτό οι ζυμώσεις διαφόρων ειδών θα μας απασχολήσουν στη συνέχεια.
ΕΝΤΥΠΗ ΕΚΔΟΣΗ